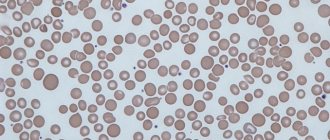

С-реактивный белок (СРБ) — это белок плазмы крови, относится к белкам острой фазы воспаления. Он участвует в процессах обезвреживания и устранения разнообразных инфекционных агентов, а также является стимулятором развития воспалительной реакции как механизма защиты организма. С-реактивный белок на поверхности чужеродной клетки соединяется со специфическими молекулами, белками, высвобождающимися из тканей, поврежденных бактериальными токсинами.
В крови, при нормальном функционировании организма, постоянно циркулирует определенное (минимальное) количество С-реактивного белка. Такой белок вырабатывается преимущественно печенью, а также внутренней выстилкой артерий. При попадании в организм чужеродных микроорганизмов (бактерии) или в результате гибели собственных тканей его концентрация существенно увеличивается. Уровень С-реактивного белка растет в сотни раз в результате тяжелой травмы, ярко выраженных воспалительных реакций, бактериальных инфекций, серьезных хирургических вмешательств или при наличии злокачественных образований.
Анализ на С-реактивный белок что показывает? Анализ крови СРБ указывает на активность реактивного белка и наличие воспалительного процесса в организме.
В Юсуповской больнице больных обеспечивают эффективной квалифицированной медицинской помощью. Врачи заинтересованы в скорейшем выздоровлении пациентов и полном восстановлении утраченных функций. Ревматологи отделения достигают значительных положительных изменений физического состояния больных, у которых имеются серьезные заболевания, это касается ревматоидных процессов, при которых повышается уровень С-реактивного белка. В собственной лаборатории Юсуповской больницы Вы можете сдать любые анализы, такие как анализ на С-реактивный белок и получить быстрые результаты.
СРБ при Covid-19
Уровень С-реактивного белка при коронавирусе – это один из ключевых лабораторных показателей, которые требуют медицинского контроля при среднетяжелой и тяжелой форме инфекции. Его обязательно определяют также у пациентов, находящихся в критическом состоянии.
Именно С-реактивный белок (С — наша буква Ц) является основным маркером поражения легких, растущим по мере увеличения тяжести инфекционного процесса и масштабности воспалительных изменений.
Уровень СРБ обязательно определяют при затрудненном дыхании, когда число вдохов ≥ 22/мин, и сатурации
Сатурация измеряется специальным прибором – пульсоксиметром.
Важные показатели крови при коронавирусе
Любое заболевание сопровождается изменениями в крови. Они носят как количественный характер (изменяется концентрация отдельных клеток в крови), так и качественный (изменения затрагивают сами клетки крови). Когда делается анализ крови при коронавирусе у человека, показатели, учитываемые врачами, могут отличаться в зависимости от состояния пациента и наличия у него хронических заболеваний. Однако, чтобы оценить состояние пациента, вызванное непосредственно присутствием в организме COVID-19, чаще обращают внимание на следующие параметры:
- лейкоцитарная формула;
- уровень гемоглобина;
- наличие факторов свертывания крови;
- сатурация кислорода в крови.
Норма
Нормальное значение С-реактивного белка не превышает 5 мг/л. Это универсальная величина, не зависящая от возраста, пола. У новорожденных детей она не должна подниматься больше 0.15 мг/л.
Если СРБ повышен, значит, в организме развивается воспаление, об интенсивности которого свидетельствует степень данного повышения.
Благодаря многолетним клиническим исследованиям и внедрению высокотехнологичных методик ученые вывели еще один параметр – так называемого «базового значения СРБ». Его уровень позволяет оценить, насколько высок риск поражения сердечно-сосудистой системы у человека.
Заметим, что указанный риск можно определить даже при отсутствии воспалительной реакции. Норма базового значения СРБ ≤ 1 мг/л.
Для максимально точных результатов рекомендуется сдавать анализ на С-реактивный белок в одной и той же лаборатории, так как в разных клиниках могут использоваться различные методики:
- ИФА – иммуноферментный анализ;
- РИД – метод радиальной иммунодиффузии;
Нефелометрия, основанная на интенсивности светового потока, рассеиваемого взвешенными частицами вещества.
Если повторные анализы сделать другими методами, то интерпретация результатов может быть неточной.
Как диагностировать коронавирус
Отвечая на вопрос, что показывает общий анализ крови при коронавирусе, следует отметить что по нему можно диагностировать только наличие воспалительного процесса и степень его тяжести. Выявить причину заболевания можно с помощью серологических реакций — иммуноферментного анализа на антитела к covid-19.
При проведении исследования можно выявить, а также оценить количество в крови специфических белков — иммуноглобулинов.
- Иммуноглобулины M. Свидетельствуют об остром течении коронавирусной инфекции. Начинают вырабатываться с 7-го дня болезни и обнаруживаются в крови до 3-4 недель от начала заболевания.
- Иммуноглобулины класса G. Начинают вырабатываться после 14 суток заболевания коронавирусом и сохраняются в крови по разным данным в течение 4-6 месяцев. Они обеспечивают иммунитет от инфекции.
В случае обнаружения в крови иммуноглобулинов М при отсутствии G диагностируется острое течение заболевания. Наличие антител обоих классов свидетельствует о том, что пациент болеет более 2 недель или вступил в период выздоровления. Наличие антител класса G говорит о том, что исследуемый переболел коронавирусом в период от 1 до 6 месяцев до проведения исследования.
При других инфекционных такие иммуноглобулины обнаруживаются также после проведения плановой вакцинации.
Для проведения анализов используется венозная кровь, которую следует сдавать утром натощак. Результат исследования становится известным в течение 1-2 суток.
Какой анализ крови показывает коронавирус? Для подтверждения диагноза при обнаружении высокого титра иммуноглобулинов M необходимо провести ПЦР-диагностику. Этот метод позволяет обнаружить генетический материал (РНК вирусы) в мазке из носо- и ротоглотки и определить является ли пациент опасным для окружающих выделителем вируса. У некоторых пациентов вирус присутствует на слизистых в течение нескольких дней, у других обнаружить фрагменты микроорганизмов удается в течение нескольких месяцев.
Чтобы диагностировать коронавирусную инфекцию, определить тяжесть ее течения, а также оценить общее состояние организма, следует проходить комплексное исследование, включающее в себя общий анализ крови, биохимию, коагулограмму, серологические исследования и полимеразную цепную реакцию.
Кому показан анализ
Тест на С-реактивный белок в обязательном порядке делается при поступлении больного в стационар и диагностировании Covid-19 как минимум средней тяжести. Далее анализ повторяют по мере необходимости.
Результаты интерпретируются в соответствии со следующими значениями:
Если на фоне приема антибиотиков существенного снижения уровня СРБ не наблюдается, то крайне высок риск летального исхода.
Выработка С-реактивного белка начинает расти в первые 5 часов после заражения и достигает своего пика ко 2-3 дню болезни.
Более детальная расшифровка результатов анализа выглядит так (мг/л):
- отрицательно –
- слабоположительно – 3-6;
- положительно – 6-12;
- резко положительно – >12.
СРБ и СОЭ
Помимо С-реактивного белка, воспалительный процесс показывает также СОЭ – скорость оседания эритроцитов. Оба этих параметра увеличиваются на ранних стадиях заболеваний, но между ними есть существенная разница.
Во-первых, СРБ появляется и исчезает быстрее, чем меняется СОЭ. Поэтому на начальных этапах диагностики он более информативен.
Во-вторых, при адекватном лечении СРБ уменьшается уже примерно через неделю, тогда как СОЭ падает не раньше чем через 2-3 недели.
В-третьих, на показатель СОЭ оказывает влияние время суток, состав плазмы крови, уровень эритроцитов, пол (у женщин СОЭ почти всегда выше). Параметр СРБ не зависит от указанных факторов.
Следовательно, анализ на С-реактивный белок является более точным методом оценки интенсивности воспалительного процесса, нежели СОЭ. Поэтому его проводят для установления диагноза, выявления острых и хронических воспалений, а также их активности. Кроме того, результаты данного анализа позволяют оценить эффективность проводимой терапии.
При СРБ >60 мг/л или его увеличении втрое на 7-14 день заболевания обязательно назначаются ингибиторы интерлейкинов – Тоцилизумаб, Сарилумаб, Канакинумаб. В тяжелых случаях, если компьютерная томограмма показала 2-3 степень поражения легких, используются следующие препараты:
- Тофацитиниб;
- Барицитиниб;
- Олокизумаб;
- Левилимаб.
Для назначения перечисленных в списке средств нужно соблюдение 2-3 пунктов из перечня ниже:
- СРБ >30 мг/л;
- падение сатурации;
- температура >38° в течение 3-х дней;
- лейкоциты (WBS)
- лимфоциты
Содержание в крови С-реактивного белка уменьшается у каждого пациента с разной скоростью. Пограничными показателями, свидетельствующими о начале выздоровления, считаются следующие:
- СРБ
- сатурация ≥ 95%;
- нормальная температура 36.6°.
При таких параметрах больного можно выписывать из больницы и переводить на амбулаторное лечение.
Когда направляют на биохимический анализ крови СРБ
Врач направляет пациента набиохимический анализ крови СРБ в следующих случаях:
- Профилактическое обследование пациентов пожилого возраста.
- Определение вероятности сердечно-сосудистых осложнений у больных диабетом, атеросклерозом, находящихся на гемодиализе.
- Обследование пациентов с гипертонической болезнью, ишемической болезнью сердца, чтобы предотвратить возможные осложнения: внезапную сердечную смерть, инсульт, инфаркт миокарда.
- Выявление осложнений после коронарного шунтирования.
- Оценка риска рестеноза, повторного инфаркта миокарда, смерти после ангиопластики у больных с острым коронарным синдромом или стенокардией напряжения.
- Контроль эффективности профилактики и лечения сердечно-сосудистых осложнений с помощью статинов и ацетилсалициловой кислоты (аспирина) у больных с кардиологическими проблемами.
- Коллагеноз (для определения эффективности терапии и реактивности процесса).
- Контроль эффективности лечения бактериальной инфекции (например, менингит, сепсис новорожденных) антибактериальными препаратами.
- Контроль эффективности лечения хронических заболеваний (амилоидоз).
- Новообразования.
- Острые инфекционные заболевания.
Особенности С-реактивного белка в пожилом возрасте
Уровень СРБ у пожилых людей может повышаться из-за возрастных изменений и на фоне сопутствующих болезней. Одна из причин – деменция, при которой С-реактивного белка становится очень много.
Старческое слабоумие наиболее часто развивается при генерализованном – общем – воспалении, связанном с атеросклерозом сосудов, высокой концентрацией триглицеридов (жиров) и липопротеинов низкой плотности.
Кроме того, при нарушении биологических процессов, обусловленных сменой дня и ночи (циркадных ритмов), и недостатке ночного сна в крови повышается содержание веществ, вызывающих воспаление. Растет при этом и уровень С-реактивного белка.
Повышение СРБ характерно для гипертонии на фоне сужения сосудов из-за холестериновых отложений, а также ожирения. Инсульт нередко является осложнением атеросклероза, который сопровождается воспалением сосудистой стенки, поэтому сразу после приступа происходит резкий выброс С-реактивного белка в кровь.
Одной из причин повышения СРБ может быть пародонтоз – воспаление десен. Причем чем выше его уровень, тем тяжелее степень пародонтоза.
Увеличенные концентрации СРБ сопровождают воспалительные патологии кишечника, связанные с нерациональным питанием и нездоровым образом жизни, а также болезнь Крона и язвенный колит.
Показания к проведению
Наиболее часто определение количества реактивного белка назначается при:
- Вычислении рисков возникновения патологий сердца и сосудов.
- После диспансеризации пожилых пациентов.
- Послеоперационном периоде.
- Оценке эффективности медикаментозной терапии.
- Диагностике заболеваний аутоиммунного и ревматического характера.
- Подозрении на опухоли.
- Инфекционных заболеваниях.
Лабораторное исследование СРБ обычно назначается при острых воспалительных заболеваниях инфекционного характера. Также он оказывает помощь при выявлении патологий аутоиммунного и ревматического характера. Его назначают при подозрении на опухоли и рак.
Роль СРБ в организме и возможные причины повышения
С-реактивный белок – это связующее звено между антигенами и иммунными клетками. При попадании в организм чужеродных агентов – вирусов, бактерий, фрагментов поврежденных клеток – в печени стартует выработка СРБ. В его задачу входит распознавание вражеского «профиля» и активация иммунного ответа.
Такой механизм действует при ряде патологий, среди которых:
- аутоиммунные – амилоидоз, ревматизм, системная красная волчанка;
- инфекционные – заражение крови (сепсис), менингит, пневмония, хламидиоз, микоплазма;
- онкологические – карцинома, меланома, лейкоз;
- глистные инвазии – лямблиоз, лейшманиоз, токсоплазмоз;
- некротические – панкреонекроз, отторжение донорского органа или ткани, астма с поражением легких, инфаркт;
- разрыв плодного пузыря при беременности, угрожающий выкидышем.
Виновник воспаления найден: S-белок коронавируса
Ученые специалисты по молекулярной биологии исследовали механизм воспалительного процесса при попадании Sars-CoV-2 в организм и выявили особую роль белка S. Именно сильное повреждение тканей (в основном легочной) является одним из наиболее грозных осложнений коронавирусной инфекции, способной привести к смерти.
В ходе исследования было установлено, что основная часть коронавирусного S-белка, либо вся его молекула могут вызвать внутритканевые повреждения, напрямую провоцируя воспаление.
Такой вывод сделала группа ученых под руководством П. Уорка из университета Ньюкасла. В нее вошли эксперты из Китая и Австралии. Результаты проведенного эксперимента были напечатаны в электронной библиотеке bioRxiv.
Оказалось, что S-белок Sars-CoV-2 обладает свойством изменять работу клеток и заставлять их синтезировать в большом объеме сигнальные молекулы, создающие условия для воспалительных процессов.
Ранее в медицинском сообществе эти воспалительные реакции считали следствием сверхактивной работы иммунной системы, чрезмерно реагирующей на коронавирус. Но открытие Уорка и его группы показало, что виновником избыточного иммунного ответа является коронавирусный белок S.
Полученные сведения ученые планируют использовать в лечении Covid-19 и протестировать ряд препаратов от онкологии. Возможно, они сумеют нейтрализовать S-белковые вирусные молекулы.
Коронавирусный S-белок как основа для вакцин
Обнадеживающие результаты получила еще одна совместная группа ученых из университета Техаса и Национального института аллергических и инфекционных болезней США под руководством Д. Маклиллана. В статье научного журнала Science в деталях описано трехмерное строение S-белка, который является ключевым элементом «Короны» Covid-19.
S-белки располагаются на поверхности вирионов – вирусных частиц. Они отходят от нее подобно лучам или иглам, благодаря чему называются Spike («шип», англ.). Именно эти белки подвергаются атакам антител, синтезируемых организмом-донором.
А самому коронавирусу S-белки нужны для заражения клеток. Их внешняя поверхность почти не отличается от знакомых клеткам молекул, что позволяет вредному микробу беспрепятственно соединяться с соответствующими рецепторами на мембранах и проникать внутрь. Именно таков механизм взаимодействия коронавирусных белков с ангиотензинпревращающим белком АПФ 2.
Применив крио-ЭМ – криогенную электронную микроскопию – ученые увидели трехмерную форму поверхности S-белка с разрешением до 3.5 А и установили, что белок меняет пространственное расположение атомов внутри молекулы: приготовившись к инфицированию, она имеет одну форму, а после связывания с клеткой-мишенью – другую.
Маклиллан и его коллеги изучали свойства первой молекулы, до ее преобразования, и установили, что соединяющийся с ферментом АПФ 2 участок белка обладает повышенной аффинностью, то есть может легко и прочно связываться с клетками, следовательно, быстро распространяться в организме.
Знания о точной структуре и свойствах S-белка позволяют увидеть новые возможности для создания эффективных вакцин и антител. Не исключено, что вакцину удастся получить даже непосредственно на основе коронавирусного S-белка, просто модифицировав его. И тогда грозная инфекция наконец сама станет мишенью.